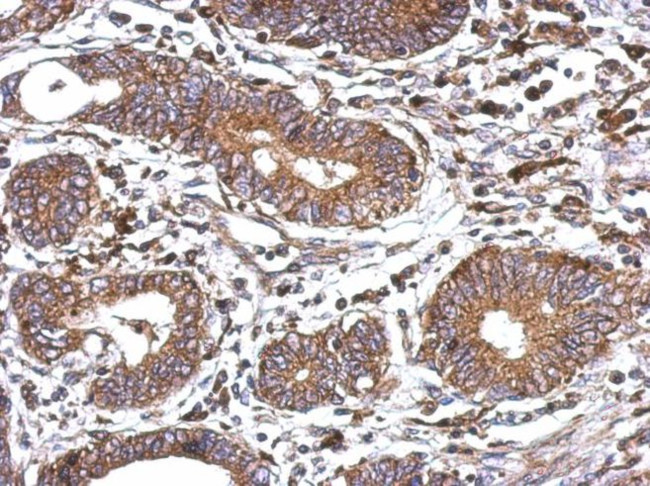
WNT6 Antibody in Immunohistochemistry (IHC)

Search
Invitrogen
WNT6 Polyclonal Antibody
{{$productOrderCtrl.translations['antibody.pdp.commerceCard.promotion.promotions']}}
{{$productOrderCtrl.translations['antibody.pdp.commerceCard.promotion.viewpromo']}}
{{$productOrderCtrl.translations['antibody.pdp.commerceCard.promotion.promocode']}}: {{promo.promoCode}} {{promo.promoTitle}} {{promo.promoDescription}}. {{$productOrderCtrl.translations['antibody.pdp.commerceCard.promotion.learnmore']}}


Please note: We are reviewing Western blot images included in the antibody testing data in our catalog, including those provided by third parties. Unless expressly labeled or annotated as “raw-unedited”, Western blot images included in the antibody testing data in our catalog may have been edited, optimized or otherwise adjusted for presentation.
产品信息
PA5-27318
宿主/亚型
分类
类型
抗原
偶联物
形式
浓度
规格
保存条件
运输条件
产品详细信息
PA5-27318 targets WNT6 in IHC (P) and WB applications and shows reactivity with Human samples.
The PA5-27318 immunogen is recombinant fragment corresponding to a region within amino acids 1 and 134 of Human WNT6.
靶标信息
The WNT gene family consists of structurally related genes which encode secreted signaling proteins. These proteins have been implicated in oncogenesis and in several developmental processes, including regulation of cell fate and patterning during embryogenesis. This gene is a member of the WNT gene family. It is overexpressed in cervical cancer cell line and strongly coexpressed with another family member, WNT10A, in colorectal cancer cell line. The gene overexpression may play key roles in carcinogenesis. This gene and the WNT10A gene are clustered in the chromosome 2q35 region. The protein encoded by this gene is 97% identical to the mouse Wnt6 protein at the amino acid level.
⚠WARNING: This product can expose you to chemicals including mercury, which is known to the State of California to cause birth defects or other reproductive harm. For more information go to www.P65Warnings.ca.gov.
仅用于科研。不用于诊断过程。未经明确授权不得转售。